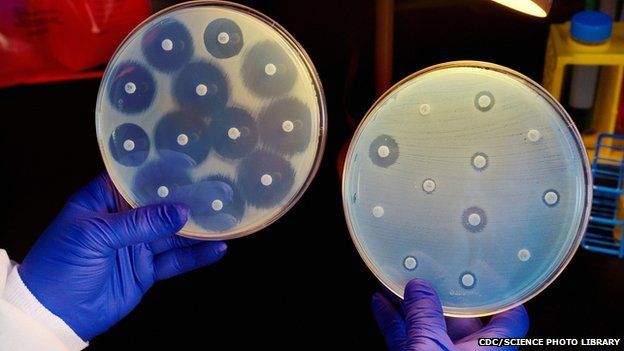

Kháng sinh có vai trò ức chế quá trình sinh tổng hợp vi khuẩn, đồng thời kìm hãm khả năng phát triển của vi khuẩn gây bệnh nên gần một thế kỷ qua kháng sinh đã trở thành “cứu cánh” trong điều trị các bệnh nhiễm trùng.Tuy nhiên trước tình trạng kháng kháng sinh ngày càng nghiêm trọng cả về phạm vi cũng như mức độ,Tổ chức Y tế thế giới (WHO) và Cục Quản lý thực phẩm và dược phẩm (FDA) Hoa Kỳ đã phải liên tục cập nhật danh mục thuốc kháng sinh và bổ sung các thuốc đặc trị bệnh truyền nhiễm phù hợp.
Ngày 6/6/2017| GENEVA|WHO cập nhật danh mục thuốc thiết yếu với những lời khuyên mới về sử dụng thuốc kháng sinh và bổ sung thêm các thuốc điều trị viêm gan C, HIV, lao và ung thư (WHO updates Essential Medicines List with new advice on use of antibiotics, and adds medicines for hepatitis C, HIV, tuberculosis and cancer). Lời khuyên mới của WHO về sử dụng kháng sinh chữa bệnh thông thường và bảo vệ những ca bệnhnặng nhất,đồng thờicập nhật danh mục thuốc thiết yếu năm 2017 và bổ sung một số loại thuốc điều trị HIV, viêm gan C, lao và bệnh bạch cầu ác tính (leukaemia)được nhiều quốc gia sử dụng để tăng cường khả năng tiếp cận thuốc và hướng dẫn các quyết định về sản phẩm mà họ đảm bảo có sẵn cho cộng đồng.

Lời khuyên mới của WHO từ nhu cầu sử dụng thuốc của cộng đồng
Danh sách này cập nhật thêm 30 loại thuốc cho người trưởng thành và 25 loại cho trẻ em, chỉ định sử dụng mới 9 sản phẩm đã được bổ sung vào danh mục, nâng tổng số lên 433 loại thuốc thiết yếu đáp ứng các nhu cầu y tếcông cộng quan trọng nhất. Danh mục thuốc thiết yếu của WHO (WHO-EML) được nhiều quốc gia sử dụng để tăng khả năng tiếp cận thuốc và đưa ra các quyết định hướng dẫn về sản phẩm được đảm bảo sẵn có cho người dân ở quốc gia của họ.TS. Marie-Paule Kieny, Trợ lý Tổng giám đốc WHO về hệ thống y tế và đổi mới(Health Systems and Innovation) cho biết: "Các loại thuốc an toàn và hiệu quả là một phần thiết yếu của bất kỳ hệ thống y tế nào,đảm bảo tất cả mọi người đều có thể tiếp cận với các loại thuốc khi cần thiết, khi nào và ở đâu họ cần là điều cốt yếu cho sự tiến bộ của các quốc gia trong bao phủ y tế toàn dân".
Lời khuyên mới của WHO với 3 nhóm kháng sinh
Lời khuyênmới cho 3 nhóm kháng sinh(New advice: 3 categories of antibiotic)
Trong bản sửa đổi lớn nhất về lĩnh vực kháng sinh trong lịch sử 40 năm WHO-EML, các chuyên gia của WHO đã phân các kháng sinh vào 3nhóm: ACCESS, WATCH và RESERVE với khuyến nghị sử dụng cho mỗi loại. Lúc đầu các nhóm mới này được áp dụng cho các kháng sinh điều trị 21 loại nhiễm trùngphổ biến nhất,nếu thấy hữu ích thì có thể mở rộng trong các phiên bản tương lai của WHO-EML để áp dụng cho các thuốc điều trị nhiễm trùng khác.Sự thay đổi này nhằm đảm bảo các thuốc kháng sinh sẵn có khi cần thiết phải được kê đơn đúng cho những trường hợp nhiễm trùng thích hợp,việc tăng cường kết quả điều trị, giảm thiểu vi khuẩn kháng thuốcphát triển và duy trì hiệu quả các thuốc kháng sinh "lựa chọn cuối cùng" (last resort)là cần thiết khi tất cả các loại thuốc khác đã thất bại.

Kháng sinh được phân nhóm theo cơ chế tác dụng
Những thay đổi này hỗ trợ “Kế hoạch hành động toàn cầu”(Global action plan on antimicrobial resistance)của WHO về kháng kháng sinh nhằm chống lại sự phát triển kháng thuốc bằng cách đảm bảo sử dụng kháng sinh hiệu quả nhất.WHO khuyến cáo các thuốc kháng sinh trong 3 nhóm:
- Nhóm ACCESS luôn sẵn có mọi thời điểmđể điều trị cho một loạt các bệnh nhiễm trùng phổ biến như amoxicillin luôn được sử dụng rộng rãi điều trị các bệnh nhiễm trùng như viêm phổi (pneumonia).
- Nhóm WATCH bao gồm các loại thuốc kháng sinh được khuyến cáo điều trị ưu tiên (first line) hay thay thế (secondline) đối với một số lượng nhỏ các bệnh nhiễm trùng như sử dụng ciprofloxacinđiều trị bệnh viêm bàng quang (cystitis)-một loại nhiễm trùng đường tiết niệu và các nhiễm khuẩn đường hô hấp trên (upper respiratory) như viêm xoang do vi khuẩn và viêm phế quản do vi khuẩn (bacterial sinusitis and bacterial bronchitis) nên giảm một cách đáng kể để tránh phát triển kháng thuốc.
- Nhóm RESERVE bao gồm các loại kháng sinh như colistin và một số cephalosporin cần được xem xét như lựa chọn cuối cùng (last-resort) và chỉ được sử dụng trong những trường hợp nghiêm trọng nhất khi tất cả các thuốc khác thất bại như các trường hợp nhiễm trùng đe dọa đến mạng sống do vi khuẩn đa kháng thuốc.

Các chuyên gia WHO đã bổ sung thêm vào danh mục 10 loại kháng sinh
Các chuyên gia WHO đã bổ sung thêm vào danh mục 10 loại kháng sinh cho người lớn và 12 loại cho trẻ em,TS. Suzanne Hill, Giám đốc dược phẩm thiết yếu và sản phẩm y tế (Essential Medicines and Health Products) cho biết của WHO: "Sự gia tăngtình trạng kháng kháng sinh bắt nguồn từ cách chúng ta sử dụng và lạm dụng các loại thuốc này,danh mục mới cập nhật của WHO sẽ giúp các nhà hoạch định hệ thống y tế và các thầy thuốc kê đơn đảm bảo những người cần thuốc kháng sinh sẽ được tiếp cận đầy đủ với chúng và đảm bảo họ có được đúng loại kháng sinh để vấn đề kháng thuốc không trở nên tệ hại hơn".

WHO bổ sung một số thuốc đặc trị bệnh truyền nhiễm
Các bổ sung khác (Other additions)
Phiên bản cập nhật về WHO-EML bao gồm một số loại thuốc mới như 2loại thuốc điều trị ung thư vùng miệng (oral cancer), một loại thuốc mới điều trị viêm gan C kết hợp từ 2 loại thuốc, một loại thuốc điều trị hiệu quả hơn cho HIV cũng như một loại thuốc cũ có thể sử dụngdự phòng nhiễm HIV ở người có nguy cơ cao, các công thức mới (new paediatric formulations of medicines)cho thuốc điều trị lao và giảm đauở trẻ embao gồm:
- Hai loại thuốc điều trị ung thư miệng (dasatinib và nilotinib) dành cho điều trị bệnh bạch cầu tủy mạn tính (chronic myeloid leukaemia)đã kháng với điều trị tiêu chuẩn (resistant to standard treatment),trong các thử nghiệm lâm sàng 1/2 số bệnh nhân đã sử dụng các loại thuốc này để đạt được kết quả khỏi bệnhhoàn toàn và bền vững (complete and durable remission from the disease);
- Sofosbuvir + velpatasvir là phương pháp điều trị kết hợp đầu tiên để điều trị tất cả 6type viêm gan C, WHO hiện đang cập nhật các khuyến cáo điều trị viêm gan C (sofosbuvir + velpatasvir as the first combination therapy to treat all six types of hepatitis C (WHO is currently updating its treatment recommendations for hepatitis C);
- Dolutegravir dành cho điều trị nhiễm HIV, đáp ứng với những bằng chứng gần đây nhất cho thấy thuốc an toàn (safety), hiệu quả (efficacy) và cản trở kháng thuốccao (high barrier to resistance);
- Dự phòng trước phơi nhiễm (pre-exposure prophylaxis_PrEP) với tenofovir đơn thuần hoặc kết hợp với emtricitabine hoặc lamivudineđể dự phòng nhiễm HIV;
- Delamanid dành chođiều trị trẻ em và thanh thiếu niên bị lao đa kháng thuốc (MDR-TB) và clofazimine cho trẻ em và người lớn bị MDR-TB;
- Các công thức kết hợp liều cố định thân thiện với trẻ em (child-friendly fixed-dose combination formulations) của isoniazid, rifampicin, ethambutol và pyrazinamide dùng trong điều trị lao phổi trẻ em;
- Miếng dán ngoài da fentanyl và methadone dùng để giảm đau ở bệnh nhân ung thư với mục đích tăng khả năng tiếp cận với các loại thuốc trong chăm sóc ung thư giai đoạn cuối (medicines for end-of-life care).

40 năm Danh mục thuốc thiết yếu của WHO được phát hành (1977-2017)
Danh mục thuốc thiết yếu (Model list of essential medicines)của WHO được phát hành từ năm 1977, đạt được sự đồng thuận của chính phủ các quốc gia tại kỳ họp của Đại Hội đồng Y tế thế giới (WHA) về “Sức khoẻ cho tất cả mọi người” (Health for all)theo nguyên tắc chỉ đạo chính sách y tế của WHO và các nước thành viên.. Nhiều quốc gia đã thông qua khái niệm về thuốc thiết yếu và phát triển danh mục của riêng mình, sử dụng WHO-EML làm hướng dẫn. WHO-EML được cập nhật và điều chỉnhđịnh kỳ mỗi hai năm (updated and revised every two years)dưới sự điều hành bởi Ủy ban chuyên gia (Expert Committee_EC)của WHO về lựa chọn và sử dụng các thuốc thiết yếu (Selection and Use of Essential Medicines).Kỳ họp của EClần thứ 21 được tổ chức từ ngày 27-31/3/2017 tại trụ sở chính của WHOđã xem xét 92 hồ sơ đăng ký đề nghị cho khoảng 100 loại thuốc và đã bổ sung thêm 55 loại thuốc vào danh mục EML (30 đối với EML chung và 25 đối với EML của trẻ em).

FDA cảnh báo về nguy cơ của kháng sinh Fluoroquinolones
FDA cảnh báovề nguy cơ của kháng sinh Fluoroquinolones
Cùng với phiên bản cập nhật thuốc thiết yếu và bổ sung các thuốc đặc trị bệnh truyền nhiễm của WHO, ngày 10/5/2017Cục Quản lý thực phẩm và dược phẩm Hoa Kỳ (FDA) cũng cảnh báo nguy cơ kháng sinh fluoroquinolon.Theo thông tin an toàn về thuốc của FDA: FDA cập nhật các cảnh báo cho kháng sinh fluoroquinolone dạng uống và tiêm do tác dụng phụ không mong muốn (FDA Drug Safety Communication: FDA updates warnings for oral and injectable fluoroquinolone antibiotics due to disabling side effects).Thông tin này là một cập nhật về an toàn dược phẩm nên FDA khuyến cáo hạn chế sử dụng kháng sinh fluoroquinolone cho một số bệnh nhiễm trùng không biến chứng (uncomplicated infections) cùngmột số tác dụng phụ có thể xảy. Theo đó, FDA đã phê duyệt những thay đổi nhãn liên quan đến cảnh báo về tác dụng không mong muốn gây khuyết tật và các thể không hồi phục khác liên quan đến thuốc kháng sinh fluoroquinolon tác dụng toàn thân do dùng đường uống hoặc tiêm.

Nhãn thuốc trước đây của fluoroquinolone đã có thông tin cảnh báo về nguy cơ
FDA cảnh báo các thuốc này có thể gây ảnh hưởng đến gân, cơ, khớp, dây thần kinh, hệ thần kinh trung ương và nhiều phản ứng có thể xảy ra trên cùng một bệnh nhân vớicác dấu hiệu và triệu chứng bao gồm đau gân hoặc đau cơ bất thường, yếu cơ, cảm giác tê rần như kiến bò hoặc cảm giác đau nhói như kim châm, tê bì ở cánh tay hoặc cẳng chân, lú lẫn và ảo giác.Bởi vì tính chất nghiêm trọng của các tác dụng không mong muốn, FDA khuyến cáo fluoroquinolon cần được lưugiữ sử dụng ở những bệnh nhân không có lựa chọn điều trị khác đối với các chỉ định viêm xoang nhiễm khuẩn, đợt bùng phát nhiễm khuẩn cấp của viêm phế quản mạn và nhiễm khuẩn tiết niệu không phức tạp do nguy cơ vượt trội lợi ích của thuốc trên những bệnh nhân này.

Với một số nhiễm khuẩn cấp, hiệu quả của fluoroquinolon vẫn cao hơn nguy cơ nên FDA
cho phép lựa chọn điều trị nhưng khuyến cáo cần thận trọng
Tuy nhiên, với một số nhiễm khuẩn cấp khác FDA xác định hiệu quả của fluoroquinolon vẫn cao hơn nguy cơ nên có thể lựa chọn điều trị,nếu bệnh nhân gặp phải tác dụng không mong muốn trong quá trình điều trị thì cần ngừng ngay thuốc và chuyển sang kháng sinh nhóm khác để điều trị thay thế.Nhãn thuốc trước đây của fluoroquinolon đã có thông tin cảnh báo về nguy cơ viêm gân, đứt gân và nặng thêm các triệu chứng trên bệnh nhân nhược cơ trong mục “hộp cảnh báo” (Boxed Warning). Ngoài ra, nhãn thuốc cũng đã có các thông tin về nguy cơ gây ảnh hưởng trên thần kinh ngoại biên, thần kinh trung ương, tim, da và các phản ứng quá mẫn do thuốc. Sau một quá trình rà soát được tiến hành năm 2013, FDA bổ sung cảnh báo về bệnh thần kinh ngoại biên có thể không hồi phục (peripheral neuropathy may be irreversible), theo đó FDA đánh giá các báo cáo thu được sau khi thuốc lưu hành trên thị trường về những trường hợp bệnh nhân trước đó khỏe mạnh gặp phải các tác dụng không mong muốn gây khuyết tật hoặc tác dụng không mong muốn nghiêm trọng, không hồi phục trên hai hoặc nhiều cơ quan trong cơ thể sau khi sử dụng các thuốc fluoroquinolon toàn thân. Các tác dụng không mong muốn này xảy ra sau khi bắt đầu sử dụng thuốc từ vài giờ đến vài tuần,tại thời điểm FDA nhận được báo cáo các tác dụng không mong muốn kéo dài từ 14 tháng đến 9 năm sau khi ngừng thuốc. Trong một số trường hợp, các tác dụng không mong muốn cải thiện sau khi ngừng thuốc nhưng một số trường hợp khác các tác dụng không mong muốn vẫn tiếp tục hoặc trở nên nặng hơn.

Trước đây, cảnh báo liên quan đến tác dụng phụ nghiêm trọng của fluoroquinolon đã được FDA phát hành tháng 7/2008
Trước đây, cảnh báo liên quan đến tác dụng phụ nghiêm trọng của fluoroquinolon đã được FDA phát hành tháng 7/2008: viêm gân và đứt gân (tendinitis and tendon rupture) và tháng 8/2013: bệnh thần kinh ngoại biên(peripheral neuropathy), đồng thời đưa ra thảo luận tại “Phiên họp Hội đồng tư vấn”(Advisory Committee meeting) của FDAvào tháng 11/2015.Nhãn mới nhất của các thuốc fluoroquinolon được FDA phê duyệt ngày 26/07/2016 đã cập nhật các thông tin cảnh báo về nguy cơ gây các tác dụng không mong muốn gây khuyết tật và các tác dụng không mong muốn nghiêm trọng, có thể không hồi phục cùng giới hạn việc sử dụng các thuốc này vào các mục “hộp cảnh báo”, chỉ định, liều dùng, cảnh báo và thận trọng.

FDA khuyến cáo nhân viên y tế cần năm vững nguy cơ của thuốc kháng sinh fluoroquinolon
Thông tin dành cho nhân viên y tế, FDA đã phê duyệt những thay đổi trong nhãn thuốc fluoroquinolon bao gồm giới hạn chỉ sử dụng fluoroquinolon điều trị viêm xoang nhiễm khuẩn cấp, đợt bùng phát nhiễm khuẩn cấp của viêm phế quản mạn và nhiễm khuẩn tiết niệu không phức tạp trên những bệnh nhân không có lựa chọn điều trị khác tại mục chỉ định, liều dùng; bổ sung nguy cơ gây tàn tật và các tác dụng không mong muốn nghiêm trọng xảy ra trên nhiều cơ quan, có thể xảy ra cùng lúc trên một bệnh nhân và không hồi phục tại các mục hộp cảnh báo, cảnh báo và thận trọng trong nhãn thuốc. Các tác dụng không mong muốn thường gặp bao gồm viêm gân, đứt gân, đau cơ, yếu cơ, đau khớp, sưng khớp, bệnh thần kinh ngoại biên và các ảnh hưởng trên thần kinh trung ương. Các tác dụng không mong muốn có thể xảy ra sau khi bắt đầu sử dụng thuốc từ vài giờ đến vài tuần,ngừng ngay thuốc khi gặp phải các tác dụng không mong muốn của thuốc. Các tác dụng không mong muốn nghiêm trọng trên hệ cơ xương và hệ thần kinh ngoại biên bao gồm viêm gân/đứt gân, đauhoặc yếu cơ, đau hoặc sưng khớp, bệnh thần kinh ngoại biênCác tác dụng không mong muốn nghiêm trọng trên hệ thần kinh trung ương bao gồm rối loạn tâm thần, lo lắng, mất ngủ, trầm cảm, ảo giác, ý nghĩ tự tử, lú lẫnCác tác dụng không mong muốn khác bao gồm nhược cơ trầm trọng hơn, khoảng QT kéo dài, phản ứng quá mẫn/phản vệ, da tăng nhạy cảm với ánh sáng, rối loạn đường huyết, tiêu chảy do Clostridium difficile. FDA khuyến cáo cán bộ y tế cần nhắc nhở bệnh nhân đọc kỹ tờ thông tin hướng dẫn sử dụng thuốc dành cho bệnh nhân khi họ được kê đơn kháng sinh fluoroquinolon và cần tăng cường báo cáo các tác dụng không mong muốn liên quan đến kháng sinh fluoroquinolon.